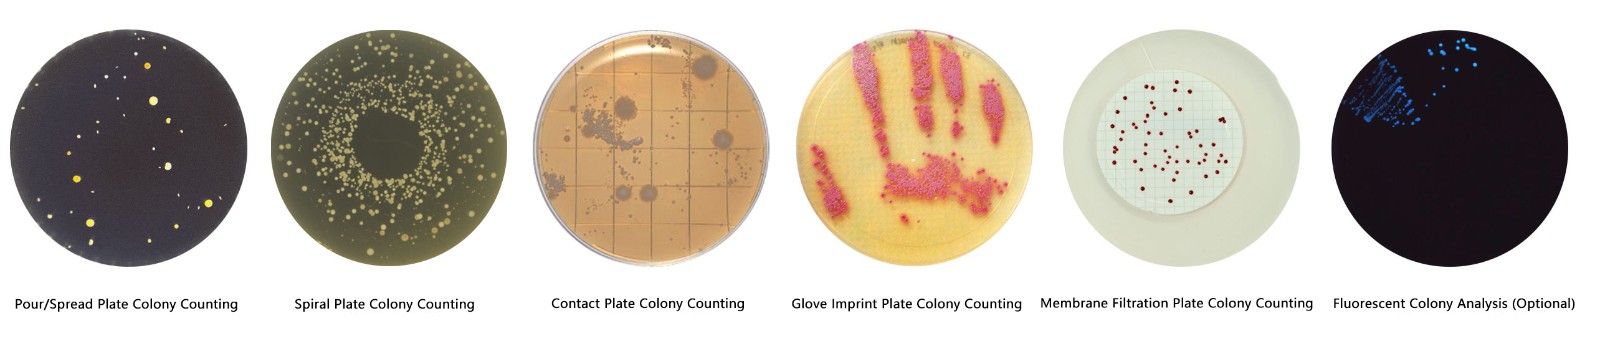
13.jpg

Intelligent colony counting workstation


The maximum throughput for a single run can reach 160 culture dishes, with a counting rate of 13 seconds per dish

Customizable report styles, real-time generation, data traceability

Automatic sampling, colony identification and analysis, generating electronic reports, with 24-hour unmanned operation throughout the process



Artificial intelligence analysis software |
By pruning neural networks, customizing loss functions and optimizers, powerful recognition and fault tolerance of colonies can be achieved, enabling the software to have good abilities in distinguishing impurities, bubbles, adhered colonies, irregular colonies, and overlapping colonies |
Embedded software system |
The core module runs safely and stably, and the analysis data is tamper proof; The computing core is built into the counter, with dual channel backup data (enterprise version) to avoid damage caused by abnormal factors such as computer viruses |
Counting type |
Support spiral coating method, pouring method, paper sheet method, membrane filtration method, contact disc counting, glove embossing counting, etc |
Colony recognition method |
A graphical simulation algorithm based on Sanitized colony morphology library comparison ensures colony counting accuracy>98% |
Sample Specifications |
55mm/60mm/90mm/120mm/150mm standard circular culture dish, automatically recognized by the system |
light source |
Built in top and bottom light sources, no need for mechanical switch control, automatic dimming, 254nm UV lamp for sample chamber disinfection (optional), 366nm UV lamp for fluorescence based colony counting (optional) |
Data export |
Support batch export of analysis results in PDF and Excel, without the need for manual tabulation, and the export format can be perfectly customized |
data transmission |
Gigabit Ethernet or WIFI wireless data transmission |
product
resource
News application
Contact Us
©2025 Punmicro scientificCopyright